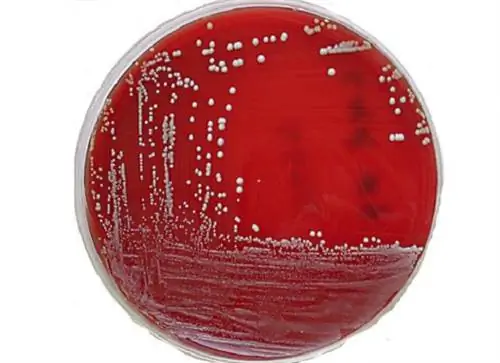
Грязные тайны отелей

СОВЕРШЕННО СЕКРЕТНО - Знаете ли вы? На пульте дистанционного управления в гостиничном номере микробов больше, чем на сиденье унитаза. В отеле дела часто идут не так хорошо, как вы думаете. Существует множество приемов кражи денег у клиентов. Благодаря этим советам вы сможете сэкономить много денег в отелях.
Избегайте горячих линий бронирования
Забронировать отели можно разными способами. Однако не следует бронировать билеты через горячие линии для клиентов. Цены здесь зачастую выше. Вместо этого позвоните напрямую в отель и заранее найдите в Интернете самое дешевое предложение. Если бронирование осуществляется напрямую, отель сохраняет комиссию, которую взимают сайты-посредники. Таким образом, цена может быть на 30 процентов дешевле.
Смерть в отеле
Гость нередко умирает во время своего пребывания. Затем предпринимается попытка как можно незаметно вывести покойного из гостиницы. Затем номер убирают, дезинфицируют и сразу передают следующему гостю.
Забронируйте вечером
Номера в отелях утром стоят дороже. Поэтому лучше всего позвонить в отель между 17:00 и 18:00 по местному времени. Тогда бронь не пришедших гостей аннулируется. Пробелы хотят заполнить, а цены снизить. С 9 вечера они снова поднимаются.
Это часто грязнее, чем вы думаете

Микры и бактерии
Уборке домашнего хозяйства нелегко. За все меньшее и меньшее время они должны вернуть блеск все большему количеству комнат. Исследование Американского университета Хьюстона показало, что выключатели света и пульты дистанционного управления являются рассадниками микробов. В некоторых случаях бактерий здесь даже больше, чем на сиденьях унитазов.
Грязные очки
Вам следует избегать стаканов в номере отеля, особенно тех, которые стоят у раковины! Потому что зачастую их лишь быстро смывают или даже вытирают той тряпкой, которая тоже использовалась для туалета. Отвратительно!
Свежие простыни, пожалуйста
Часто бывает, что к моменту вашего прихода в номер меняются только чехлы на подушке и одеяле, а простыня уже использована. Это не совсем желательно.
Шампунь и Ко можно брать с собой

Предметы гигиены
Отели ожидают, что гости заберут предоставленные им туалетные принадлежности. Поскольку открытые бутылки не подлежат вторичной переработке, можно упаковывать лосьон для тела и гель для душа.
Кофейная кружка с эжектором микробов
Кофейные чашки многие уборщики ополаскивают только водой, без использования моющих средств. Таким образом, бактерии не могут легко передаваться от гостя к гостю. Это не совсем безобидно.
Отмена без комиссии
Если вы отмените бронирование в отеле, вам, как правило, все равно придется оплатить часть или даже полную стоимость. Но есть способ обойти эти сборы. Сначала отложите свое пребывание на несколько недель. Через несколько дней вы снова звоните и отменяете бронь. Таким образом, вы сможете сэкономить на комиссиях. К сожалению, этот трюк не работает, если поездка уже оплачена заранее.
Овербукинг
Овербукинг на рейсы - обычное дело. Отели также переняли этот обычай. Потому что иногда гости вообще не появляются. Если прибудут все группы, гостей придется разместить в другом жилье.
Доверьтесь консьержу
тебя не должно быть слишком много. Потому что, если вы спросите его о лучшем баре или самом вкусном ресторане, ему не обязательно говорить правду. Часто консьерж получает комиссию из разных мест. Неважно, насколько вкусна там еда.
Номер на верхнем этаже
У комнаты на верхнем этаже есть только преимущества: часто там более высокие потолки, а шумовое загрязнение значительно ниже. Угловые комнаты также больше остальных.
В мини-баре нет собственных напитков

напитки в мини-баре
Не кладите свои напитки в мини-бар! Обычно они проверяются. За размещение собственных напитков в холодильнике может взиматься плата. Если вы берете напитки, сначала убедитесь, что они правильно запечатаны! Некоторые гости просто наполняют открытые бутылки водой